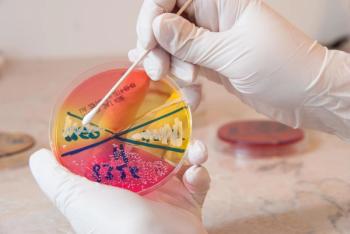

TIFFANY LEE, PHARMD
Advertisement
Articles by TIFFANY LEE, PHARMD
Advertisement
Latest Updated Articles
Analysis on Use on MRSA Nasal Swabs to Rule Out MRSA PneumoniaPublished: June 1st 2018 | Updated:
Advertisement
Advertisement
Trending on Pharmacy Times
1
TrumpRx Launches, Offering Cash-Paying Patients Discounted Drugs
2
Enlicitide Meaningfully Lowers LDL-C at 24 Weeks in Patients At Risk for ASCVD Events
3
SGLT2 Inhibitors in T2D Lower 5-Year Risk of CKD and Acute Kidney Injury
4
Pharmacist Takeover: CAR T Therapy Signals a Shift in ALL Treatment
5
